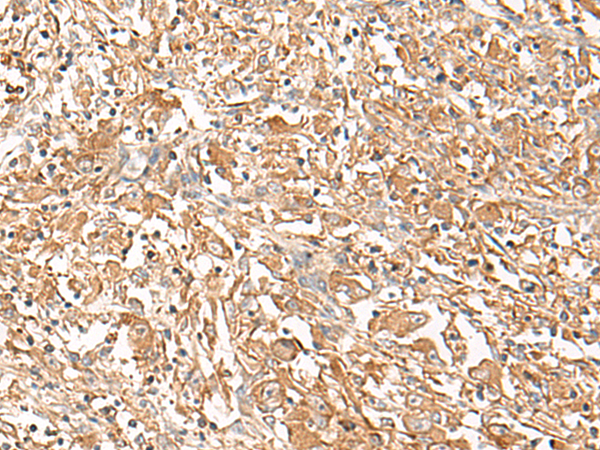

中文名稱: 兔抗CORO2A多克隆抗體
|
Background: |
This gene encodes a member of the WD repeat protein family. WD repeats are minimally conserved regions of approximately 40 amino acids typically bracketed by gly-his and trp-asp (GH-WD), which may facilitate formation of heterotrimeric or multiprotein complexes. Members of this family are involved in a variety of cellular processes, including cell cycle progression, signal transduction, apoptosis, and gene regulation. This protein contains 5 WD repeats, and has a structural similarity with actin-binding proteins: the D. discoideum coronin and the human p57 protein, suggesting that this protein may also be an actin-binding protein that regulates cell motility. Alternative splicing of this gene generates 2 transcript variants. |
|
Applications: |
ELISA, IHC |
|
Name of antibody: |
CORO2A |
|
Immunogen: |
Fusion protein of human CORO2A |
|
Full name: |
coronin 2A |
|
Synonyms: |
IR10; WDR2; CLIPINB |
|
SwissProt: |
Q92828 |
|
ELISA Recommended dilution: |
5000-10000 |
|
IHC positive control: |
Human lung cancer and Human liver cancer |
|
IHC Recommend dilution: |
20-100 |

購物車
幫助
021-54845833/15800441009
